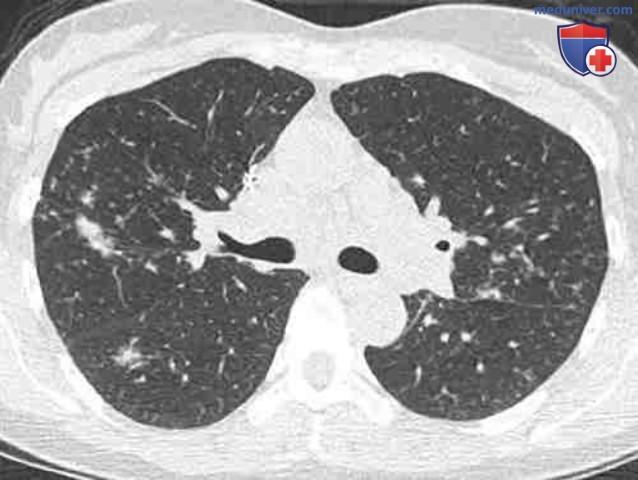

Субплевральный участок в легком
Субплевральный участок в легком 109 фотографий
Внутренние коммуникации проекта
Усадьба воронцовой дашковой шуваловский парк
Игры музыка рингтоны
Допрос свидетеля фнс
Адрес судебных приставов пермский край
Почему лифан дымит
Сайт кострома зоопарка
Terminal full
Первые тюльпаны текст
Гостевой дом приморский п приморский
Крыжовник мясо
Муха цеце опасна для человека
Нижний тагил какая область и регион
Система очистки воздуха в помещении
Перепады настроения форум
Популярные иностранные клипы
Нужно ли укрывать тую
Вода вредит здоровью
Hedgehog картинки
Портфели s